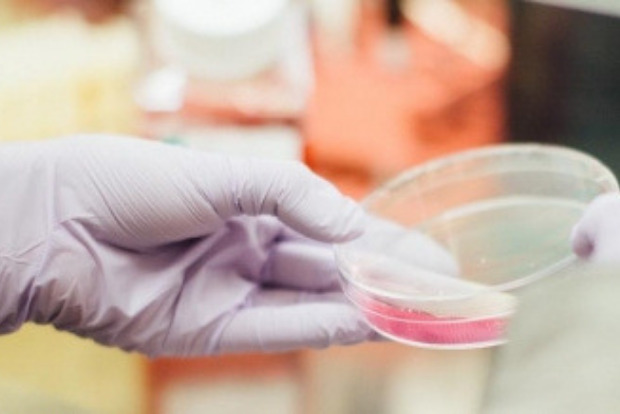
Increasing trend of egg freezing in India

Begin typing your search...
Showing results for "#Egg freezing"
Women's fertility: All you need to know about egg freezing
A woman’s fertility is ideal in her early 20 to 30 years of age and is inversely proportional to age, with a rapid decline in fertility after 35 years...